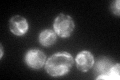
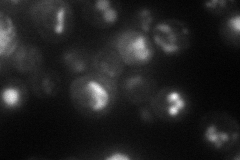
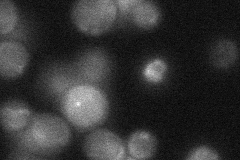
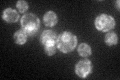

View description
Delta subunit of the oligosaccharyl transferase glycoprotein complex, which is required for N-linked glycosylation of proteins in the endoplasmic reticulum
Localization:
Intensity:
Fold change:
Significance:
-
C’ GFP library in SD
ER75.58 -
N' NOP1pr-GFP in SD

ER,vacuole81.86 -
N' TEF2pr-mCherry in SD
cell periphery,vacuole48.7596 -
N' NATIVEpr-GFP in SD
below threshold25.4439 -
N' TEF2pr-VC and Cyto-VN in SD

#N/A0 -
C’ GFP library in SD+DTT

ER96.811.28No -
C’ GFP library in SD+H2O2

ER63.410.83No -
C’ GFP library in Starvation Media
ER73.520.97No -
C’ GFP library on the background of Pup2-DaMP

ER -
C’ GFP library on the background of CCT mutant

ER64.55520.854037No
